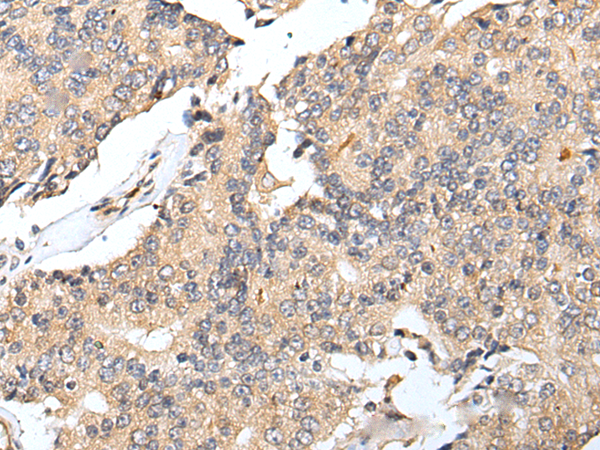

中文名稱: 兔抗RNF141多克隆抗體
英文名稱: Anti-RNF141 rabbit polyclonal antibody
抗 原: RNF141
相關(guān)類別: 一抗
儲(chǔ) 存: 冷凍(-20℃)
宿 主: Rabbit
反應(yīng)種屬: Human, Mouse, Rat
標(biāo) 記 物: Unconjugate
克隆類型: rabbit polyclonal
技術(shù)規(guī)格
|
Background: |
The protein encoded by this gene contains a RING finger, a motif known to be involved in protein-DNA and protein-protein interactions. Abundant expression of this gene was found in the testicular tissue of fertile men, but was not detected in azoospermic patients. Studies of the mouse counterpart suggest that this gene may function as a testis specific transcription factor during spermatogenesis. |
|
Applications: |
ELISA, IHC |
|
Name of antibody: |
RNF141 |
|
Immunogen: |
Full length fusion protein |
|
Full name: |
ring finger protein 141 |
|
Synonyms: |
ZFP26; ZNF230 |
|
SwissProt: |
Q8WVD5 |
|
ELISA Recommended dilution: |
5000-10000 |
|
IHC positive control: |
Human prostate cancer and Human lung cancer |
|
IHC Recommend dilution: |
25-100 |
購(gòu)物車
購(gòu)物車 幫助
幫助
 021-54845833/15800441009
021-54845833/15800441009
